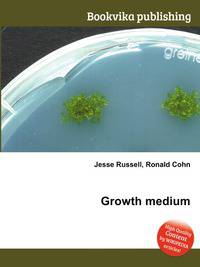
Growth medium

Поиск книг, учебников, пособий в онлайн-магазинах
Growth medium
Автор: Jesse Russell,Ronald Cohn, 94 стр., издатель: "Книга по Требованию", ISBN: 978-5-5108-9931-3High Quality Content by WIKIPEDIA articles! A growth medium or culture medium is a liquid or gel designed to support the growth of microorganisms or cells, or small plants like the moss Physcomitrella patens. There are different types of media for growing different types of cells. Данное издание представляет собой компиляцию сведений, находящихся в свободном доступе в среде Интернет в целом, и в информационном сетевом ресурсе "Википедия" в частности. Собранная по частотным запросам указанной тематики, данная компиляция построена по принципу подбора близких информационных ссылок, не имеет самостоятельного сюжета, не содержит никаких аналитических материалов, выводов, оценок морального, этического, политического, религиозного и мировоззренческого характера в отношении главной тематики, представляя собой исключительно фактологический материал.
| В наличии: | ||||
|
|
Sprinter - 894 руб. |
Перейти 
|
 Лучшая цена Лучшая цена
|
|
|
|
Books.Ru - 1001 руб. |
Перейти 
|
||
| Под заказ: | ||||
|
|
OZON.ru - 998 руб. |
Перейти 
|
||
Рейтинг книги: 


 4 из 5, 3 голос(-ов).
4 из 5, 3 голос(-ов).



 4 из 5, 3 голос(-ов).
4 из 5, 3 голос(-ов).



